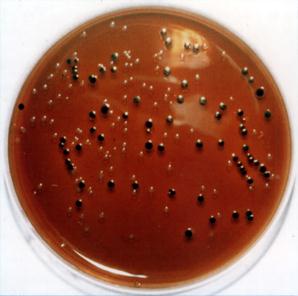

Рекомендуемая литература
1. Борисов Л.Б. Медицинская микробиология, вирусология и иммунология: Учебник / М.: Медицина, 2005
2. Коротяев А.И., Бабичев С.А. Медицинская микробиология, иммунология и вирусология: Учебник. – Спб.: Спец лит, 2008
3. Медицинская микробиология, вирусология и иммунология: Учебник / Под ред. А.А.Воробьева. – М.: ООО Медицинское информационное агентство, 2008
4. Медицинская и санитарная микробиология. Учебное пособие для студентов высших медицинских учебных заведений. Гриф УМО по медицинскому образованию, 2010 г.*
Кривошеин Ю.С., Воробьев А.А., Широбоков В.П.
5. Медицинская микробиология, вирусология и иммунология. В 2 томах. Том 2, 2010 г.*
Зверев В.В., Бойченко М.Н.
6. Поздеев О.К. Медицинская микробиология / Под ред. В.И.Покровского – М.: ГЭОТАР-Медиа, 2010
7. Руководство к практическим занятиям по медицинской микробиологии, вирусологии и иммунологии/Под ред. О.В.Бухарина. –М.: Медицина, 2002
8. Руководство к практическим занятиям по медицинской микробиологии, вирусологии и иммунологии/Под ред. В.В.Теца. –М.: Медицина, 2002
ПРИЛОЖЕНИЕ – ЦВЕТНЫЕ ВКЛАДКИ
|  |
| Рис. 1. Термостат | Рис. 2. Ламинарный шкаф |
 |  |
| Рис 3. Микроскоп Биомед С2 | Рис. 4. Люминесцентный микроскоп |
 | | Рис. 5. Морфология микробов. А – кокки (1 – микрококки, 2- диплококки: гонококки и менингококки, 3 – диплококки: пневмококки, 4 – тетракокки, 5 – стафилококки, 6 – стрептококки, 7 - сарцины); Б - палочки (1 – энтеробактерии, 2 – дифтерийная палочка, 3 – сибиреязвенная палочка, 4 – палочка чумы, 5 - столбнячная палочка); В – извитые формы (1 – холерный вибрион, 2 - спириллы, 3 – бледная трепонема, 4 –боррелии, 5 – лептоспиры); Г – актиномицеты (1, 2- прямые спороносцы, 3- непрямые спороносцы, 4 – одноклеточный мицелий) | |
| |
 |  |
| Рис. 6. Saccharomyces cerevisiae. Окраска метиленовым синим | Рис. 7. Staphylococcus aureus Окраска по Граму. Гр(+) |
 |  |
| Рис. 8. Esherichia coli. Окраска по Граму. Гр(-) | Рис.9. Streptococcus pyogenes Окраска по Граму. Гр(+) |
 |  |
| Рис. 10. Vibrio cholerae. Окраска по Граму. Гр(-) | Рис. 11. Bacillus cereus. Окраска по Граму. Гр(+) |
 |
| Рис. 12. Окраска по Граму. Грамотрицательные палочки, грамположительные стафилококки |
 |
| |
| Рис. 13. Ультраструктура бактериальной клетки. 1 - капсула, 2 - оболочка, 3 - цитоплазматическая мембрана, 4 - нуклеоид, 5 - базальное тело, 6 - жгутики, 7 -рибосомы, 8 -цитоплазма, 9 - пили, 10 – включения, 11- мезозома |
 |  |
| Рис. 14. Corynebacterium diphtheriae. Окраска по Нейссеру | Рис. 15. Оболочка дрожжей |
 |  |
| Рис 16. Нуклеоид Bacillus subtilis | Рис.17. Капсулы Klebsiella pneumonae. Окраска по Гинсу-Бурри |
 |  |
| Рис. 18. Mycobacterium tuberculosis. Окраска по Цилю-Нильсену. | Рис. 19. Споры Bac. subtilis. Окраска по Ауески |
 |  |
| Рис. 20. Актиномицеты | Рис. 21. Риккетсии в цитоплазме эукариотов |
 |
| Рис. 22. Питательные среды для культивирования бактерий |
 |  |
| Рис. 23. Лактозопозитивные и лактозонегативные колонии энтеробактерий на среде Левина |
 |
| Рис. 24. Пигменты бактерий | Рис. 25. Анаэростат |
 |  |
| Анализатор стерильности крови BD BАCТЕC | Полуавтоматический анализаторAutoScan |
 |  |
| Полуавтоматический анализатор BBL Crystal | Полуавтоматический анализатор mini API |
 |  |
| Автоматический анализатор VITEK 2 | Автоматический анализатор BD Phoenix |
| Рис. 26. Бактериологические анализаторы |
 а а  б б  в в |
 г г |
| Рис. 27. Стрипы для биохимической идентификации бактерий (а,б,в) и определения антибиотикорезистентности (г) |
 |  |
| Амплификатор | Прибор для гель-электрофореза |
 |  |
| Трансиллюминатор | Флюориметр |
| Рис. 28. Оборудование для полимеразной цепной реакции - ПЦР |
 |  |
| Рис. 29. Проба на чувствительность микробов к антибиотикам (метод бумажных дисков) | Рис. 30. Е-тест на чувствительность микробов к антибиотикам |
 |  |
| Рис. 31. Импактор «Флора-100» | Рис. 32. Аппарат Кротова |
 |
| а | б |
| Рис. 33. Ориентировочная реакция агглютинации на стекле (а - положительная реакция культуры бактерий с соответствующей агглютинирующей сывороткой, б – контроль культуры с физиологическим раствором, реакция отрицательна) |
 |
| Рис. 35. Незавершенный фагоцитоз гонококка |
| |
| Рис. 36. Схема РСК. а – положительный результат (задержка гемолиза), б – отрицательный результат (гемолиз) |
| | | | | Культура клеток Центрифугирование Электрофорез Перенос антигенов на бумагу Обработка сывороткой пациента, постановка ИФА Учет | |
 | |  | Результаты иммуноблотинга считаются положительными при обнаружении антител к р24, р31, gp41, Gp120. Положительный результат (наличие антител к ВИЧ) характеризуется светло-коричневым окрашиванием содержимого лунки.  Иммуноферментный анализ Иммуноферментный анализ | | |
| Рис 38. Иммуноблотинг |
 |
| Рис. 39. Иммуноферментный анализатор |
 |
| Рис. 40. Проточный цитофлюориметр |
| №№ | Тема и содержание занятия |
| 1. | Морфология микроорганизмов. Микроскопический метод исследования микроорганизмов. Простые методы окраски бактерий. Правила работы и устройство микробиологической лаборатории |
| 2. | Морфология микроорганизмов. Структура бактериальной клетки. Сложные методы окраски. Окраска по Граму. |
| 3. | Морфология микроорганизмов. Структура бактериальной клетки. Сложные методы окраски. Изучение производных бактериальной клетки. |
| | Морфология и классификация бактерий, спирохет, риккетсий, хламидий, микоплазм и актиномицетов. |
| 5. | Современные методы стерилизации и дезинфекции. Контроль стерилизации. |
| 6. | Физиология микроорганизмов. Питание бактерий. Питательные среды для культивирования бактерий. |
| 7. | Физиология бактерий. Рост и размножение бактерий. Скорость и фазы роста бактерий. Методы культивирования анаэробов |
| 8. | Бактериологический метод исследования. Методы выделения чистых культур. Методы идентификации бактерий. Ферменты микроорганизмов и их практическое применение. |
| 9. | Вирусы бактерий (бактериофаги). Бактериофагия. Практическое применение бактериофагов |
| 10. | Генетика микроорганизмов. Генетический метод диагностики инфекций. Основы биотехнологии. |
| 11. | Микробиологические основы химиотерапии инфекционных болезней. Методы определения чувствительности микроорганизмов к антибактериальным препаратам. |
| 12. | Экология микроорганизмов. Микрофлора воздуха, воды, почвы |
| 13. | Экология микроорганизмов. Микрофлора организма человека. |
| 14. | Итоговое занятие (1 модуль). |
| 15. | Учение об инфекции. Факторы патогенности бактерий. Роль макроорганизма, внешней среды и социальных условий в развитии инфекции. Формы инфекции. Биологический метод диагностики инфекционных болезней |
| 16. | Иммунитет. Виды иммунитета. Антигенные свойства бактерий. Серологический метод диагностики инфекций (РА, РНГА, РП, РСК |
| 17. | Серологический метод диагностики инфекций (РН, МИФ, РИА, ИФА). |
| | Медицинские иммунобиологические препараты для профилактики и лечения инфекционных болезней. Аллергический метод диагностики. |

а
а  б
б  в
в  г
г 














 2015-01-21
2015-01-21 3297
3297






 Тест-система
Тест-система 








 КОМПЛЕМЕНТ
КОМПЛЕМЕНТ 


 Иммуноферментный анализ
Иммуноферментный анализ